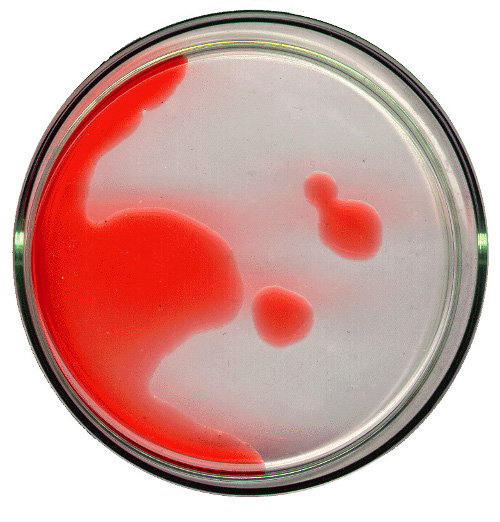

La gravità della sclerosi multipla può variare a seconda delle stagioni, suggerisce un nuovo studio di ricercatori statunitensi.
La sperimentazione, realizzata presso il Brigham and Women’s Hospital di Boston ha infatti dimostrato, grazie all’uso della risonanza magnetica, che vi sono più alti livelli di attività del disturbo durante i mesi primaverili ed estivi.
Anche se il motivo di ciò non è chiaro, secondo i ricercatori quanto osservato potrà essere utile in futuro per la sperimentazione dell’efficacia di nuovi farmaci, che potrebbero essere testati nella loro validità considerando anche questa variabile, finora non presa in considerazione.
La sperimentazione, realizzata presso il Brigham and Women’s Hospital di Boston ha infatti dimostrato, grazie all’uso della risonanza magnetica, che vi sono più alti livelli di attività del disturbo durante i mesi primaverili ed estivi.
Anche se il motivo di ciò non è chiaro, secondo i ricercatori quanto osservato potrà essere utile in futuro per la sperimentazione dell’efficacia di nuovi farmaci, che potrebbero essere testati nella loro validità considerando anche questa variabile, finora non presa in considerazione.